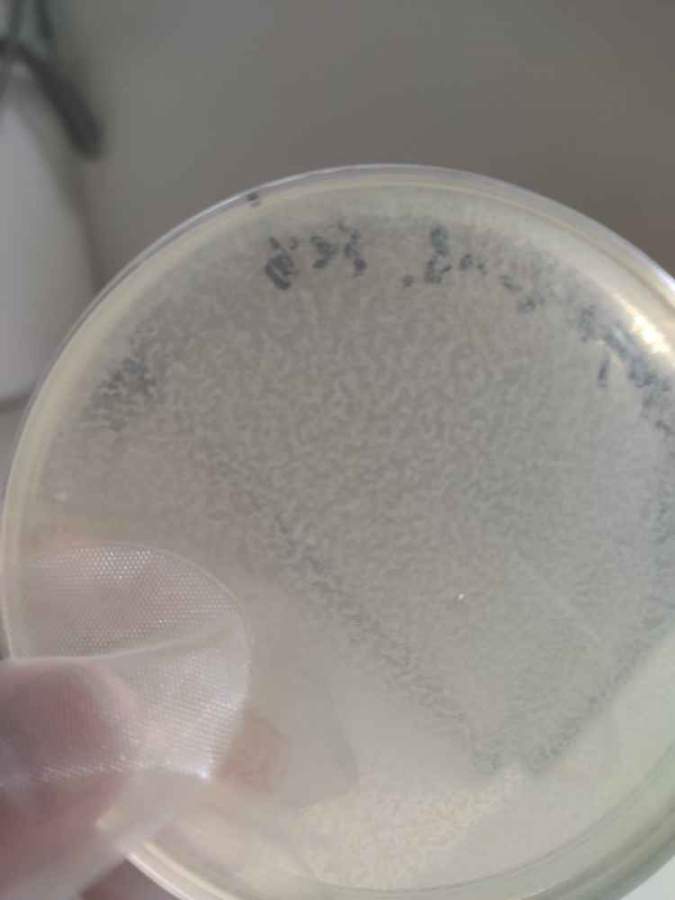

活性污泥系统中的微生物

charliechu
大家好!我们现在有一个处理污水的活性污泥(起主要功能的是系统中的细菌)系统,最近发现似乎有一类非细菌的生物在系统中爆发式增长,对系统的效果似乎有严重影响,推测它的爆发在大...
微生物
- 300
- 6
厌氧培养过程中刃天青的颜色变化
hellomethan
在配置厌氧培养液时,向培养液中加入刃天青,然后加入盐酸半胱氨酸,颜色由蓝色变成紫红色,变成橙色变成无色。以前配置都是由蓝色变成紫红色变成粉红色变成无色。请问是什么原因怎么会呈现橙色的呢?
微生物
- 650
- 13
大肠杆菌催化能力
big_tomato
我的菌株是大肠杆菌BL21*,里面有自己构建的质粒,从平板挑点活化催化后几次效果都还可以,不过后面几次的催化能力明显下降,产量减少了10倍,想问一下是大肠杆菌的问题还是因为质粒的问题急求急求啊
微生物
- 300
- 6

京公网安备 11010802022153号
京公网安备 11010802022153号